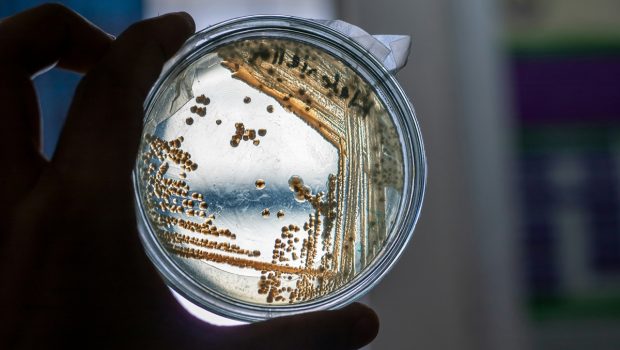

A kutatók célja, hogy az Akkermansia muciniphila baktérium hatását embereken is bizonyítsák, miután egereken sikeresen csökkentették a súlyt anélkül, hogy az étrend változott volna.
A közelmúltban végzett kutatások új reményt adnak az elhízás és a cukorbetegség elleni küzdelemben. A legújabb tanulmány célja , hogy embereken is igazolják, hogy a baktériumok, különösen az Akkermansia muciniphila, használhatóak a túlsúly és a betegségek megelőzésére . Az emberi szervezet tele van mikrobákkal, aminek mennyisége tízszerese a sejtekkel való számnak , és egyre több bizonyíték utal arra, hogy ezek a parányi organizmusok különböző módon befolyásolják egészségünket.
A kutatások során jelentős eltérést figyeltek meg a sovány és túlsúlyos emberek bélbaktériumainak összetételében. Korábbi tanulmányok már megállapították, hogy a gyomor bypass műtétek után a bélbaktériumok egyensúlya megváltozik.
Belga kutatók ezúttal az Akkermansia muciniphila évfolyamatára magas zsírtartalmú táplálékot kaptak , majd az említett baktériummal kezelték őket, megfigyelték, hogy súlyuk felét elveszítették, anélkül, hogy étrendjükben jelentős változás történt volna. Az eredmények alapján a kutatók bizakodóak, hogy ennek a baktériumnak a szerepe az elhízás kezelésében embereknél is meghatározó lehet.